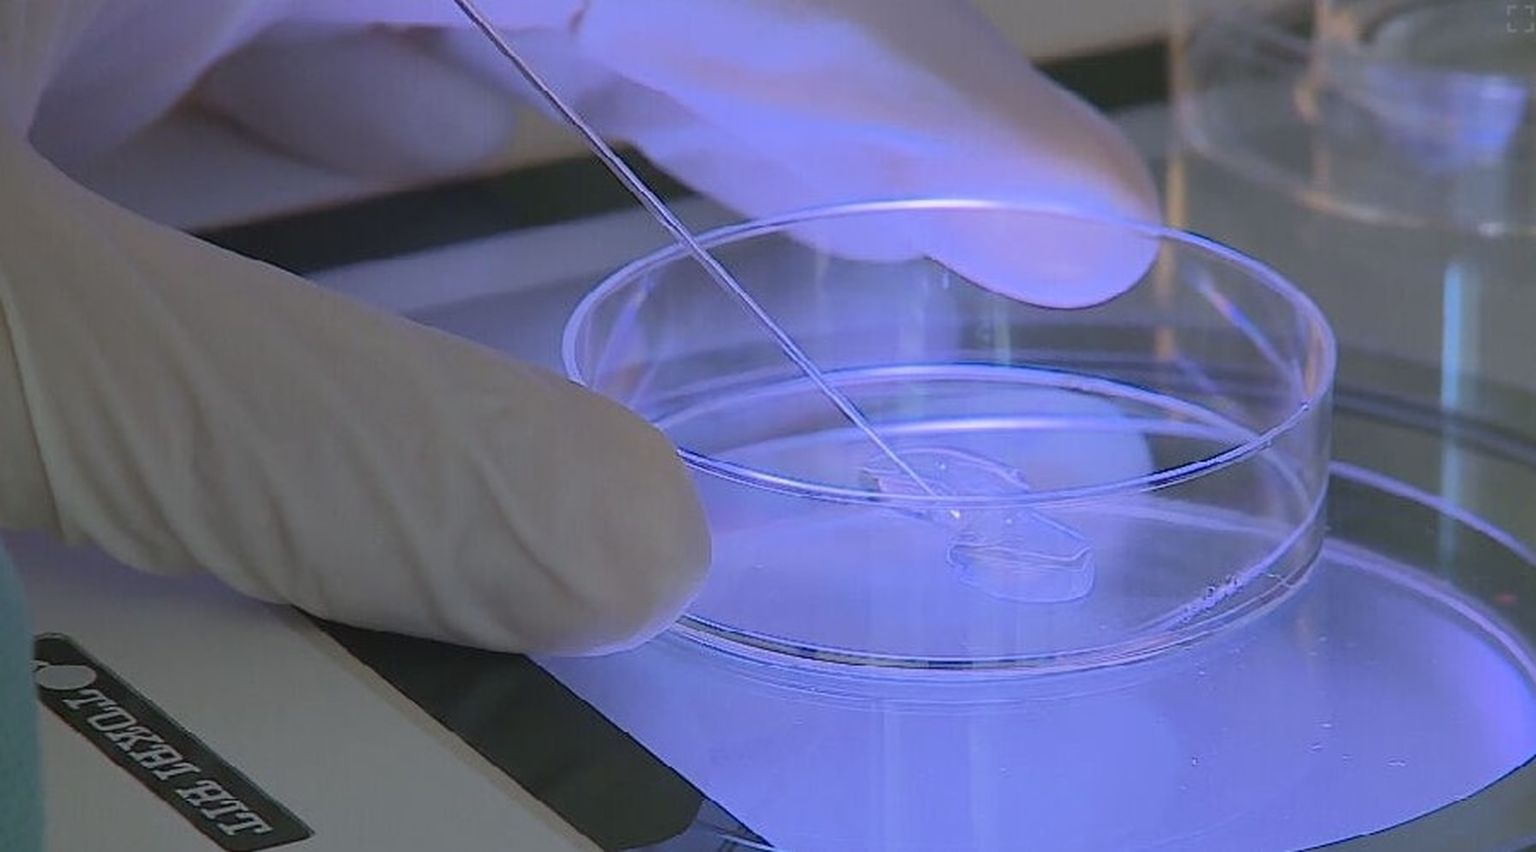

-
 Prva beba s tri roditelja, ilustracija - 1 Foto: DNEVNIK.hr
Prva beba s tri roditelja, ilustracija - 1 Foto: DNEVNIK.hr -
Prva beba s tri roditelja, ilustracija - 2 Foto: DNEVNIK.hr
Prva beba s tri roditelja, ilustracija - 2 Foto: DNEVNIK.hr -
 Prva beba s tri roditelja, ilustracija - 3 Foto: DNEVNIK.hr
Prva beba s tri roditelja, ilustracija - 3 Foto: DNEVNIK.hr -
 Prva beba s tri roditelja, ilustracija - 4 Foto: DNEVNIK.hr
Prva beba s tri roditelja, ilustracija - 4 Foto: DNEVNIK.hr -
 Prva beba s tri roditelja, ilustracija - 5 Foto: DNEVNIK.hr
Prva beba s tri roditelja, ilustracija - 5 Foto: DNEVNIK.hr -
Pogledaj i ovo


Međunarodni projekt IMforFuture
"Sat" koji pokazuje koliko biste dugo mogli živjeti doista postoji. A ovi hrvatski znanstvenici znaju (skoro) sve o njemu



 +
1
+
1

DNK NAŠ SVAGDAŠNJI
Forenzičari nakon više od dva desetljeća složili mozaik četverostrukog ubojstva: Istražitelje je trag odveo do 56-godišnjeg Hrvata



 +
4
+
4

Žrtve masovnih grobnica
Emotivno na obljetnici primjene DNK tehnologije: "Ljudi vas pitaju, ‘Je li to stvarno moj sin?’, a vi imate dva komadića izgorena tkiva"

